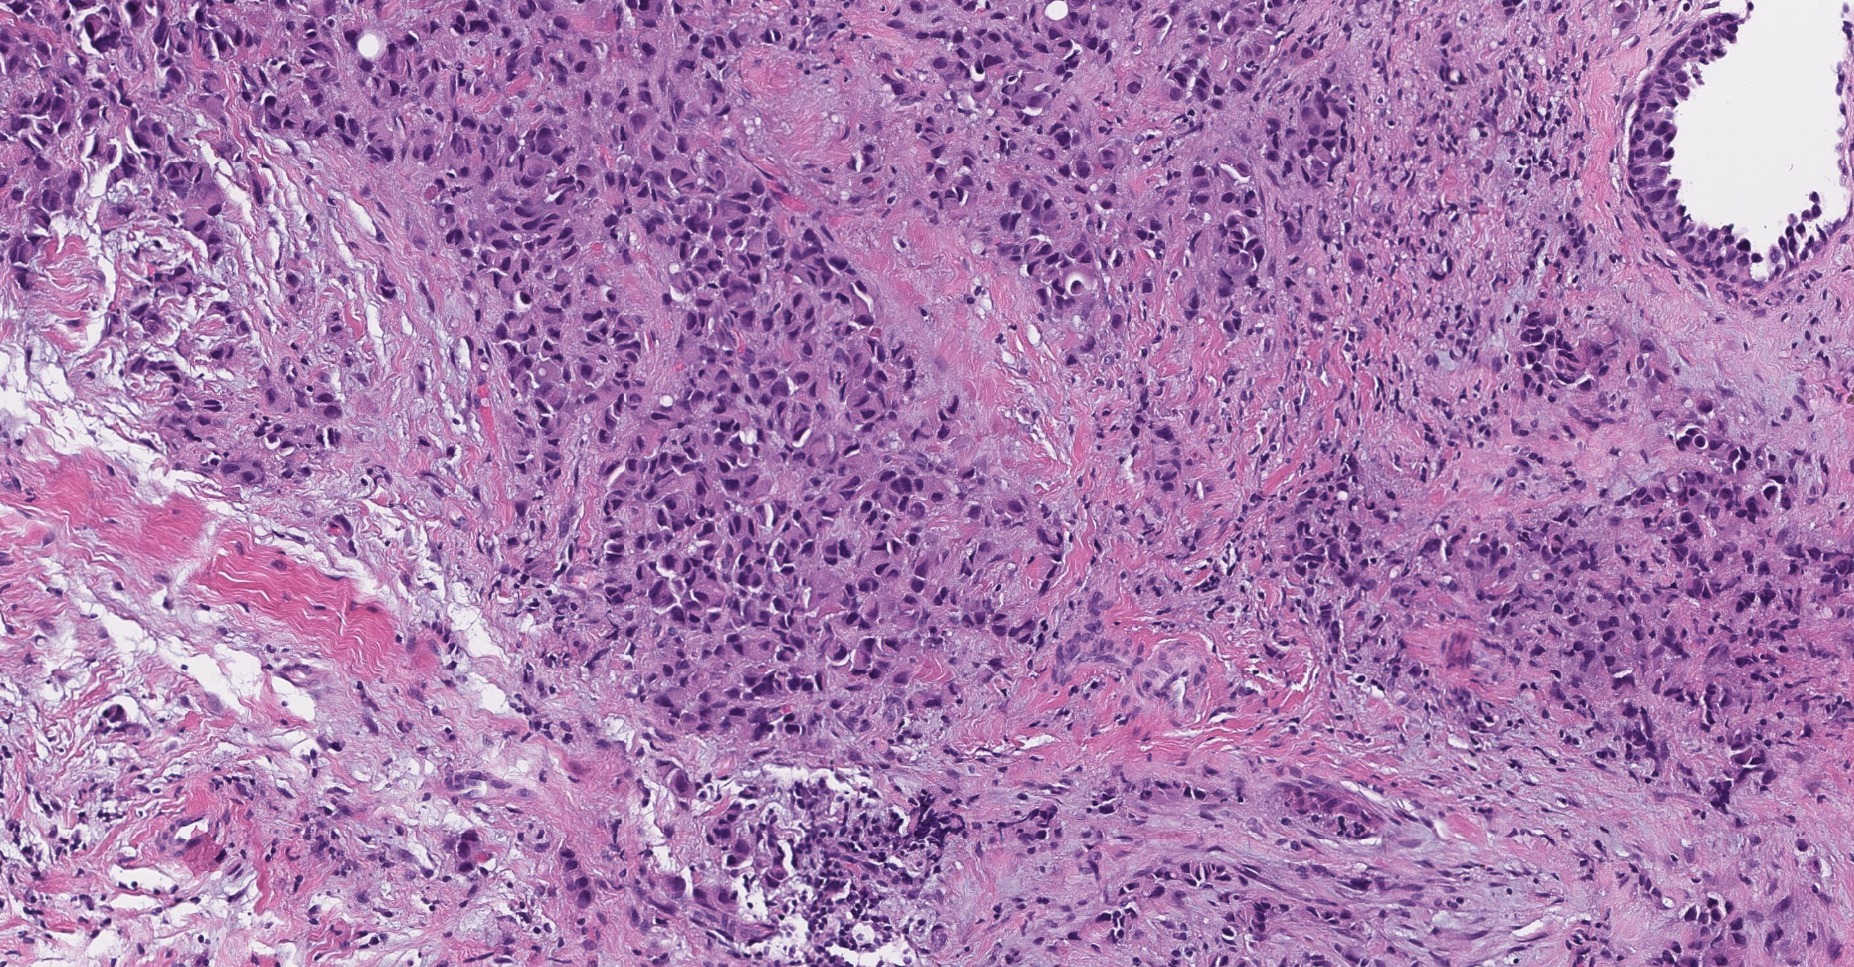
Home Image
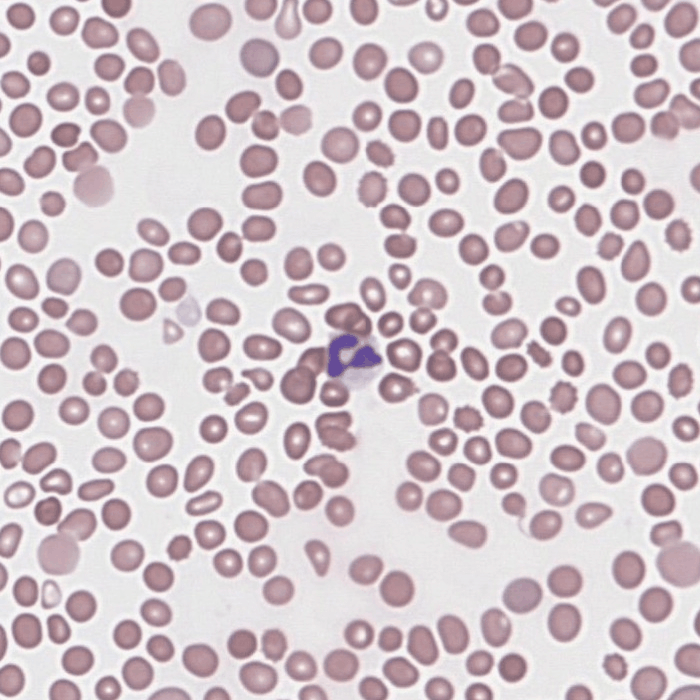
image-2

Contact
RippleSoft Ltd
Explore the endless possibilities of automated image processing
We empower researchers to unlock the full potential of biological data through intelligent automation. By combining domain-specific expertise with state-of-the-art AI technologies, we enable unprecedented insight into complex biological systems. Our platforms go beyond manual analysis, delivering scalable, high-throughput solutions that accelerate discovery and deepen scientific understanding.

Take your biological research to the next level with AI-powered image analysis and automation. Our solutions are designed to enhance the precision, speed, and scalability of working with complex samples. Whether you're exploring cellular morphology or large-scale clinical data, we provide the tools to extract deeper insights with minimal manual effort.
Our solutions integrating advanced artificial intelligence in the clinic and research support life sciences by a deeper understanding of data in various domains. Our automated image analysis solutions enable fast, accurate, and reproducible evaluation of biological and clinical samples utilizing deep learning algorithms for precision and performance.
We process images of all kinds. As for medical imaging both structural and functional modalities like MRI, CT, PET, UH and X-ray are supported. Microscopy imaging for laboratory purposes offered in our portfolio include histopathology (H&E, IHC), cytology (e.g. pap smear), blood smear, cell culture and fertility/IVF. Regarding research we create solutions for brightfield and fluorescent microscopy, high-content screening, pharmaceutical testing, bacteria colony counting etc.
Handling large amounts of imaging data is carefully performed by developing software tools that smoothly fit into the workflow to accelerate scientific progress, discovery or diagnosis. Applying cutting-edge AI-driven approaches to process data we offer reliable and accurate quantitative analysis from raw input to conclusions whether for detection, classification, segmentation or tracking. We help the experts find tumours, anomalies, cellular response and insight with a personalized and supportive solution.

AI-powered medical & digital image analysis
We develop state-of-the-art AI solutions for the automatic segmentation (e.g. tissue region, single cell), object detection (e.g. target cell, bacteria), classification (e.g. healthy vs malignant), tracking (e.g. movement) and progress monitoring (e.g. cell growth, confluence) of images.
Custom AI model development
We design and train and validate custom deep learning models (neural networks) tailored to your specific research or clinical use case collaborating with clinicians/researchers.
Data annotation & processing
High-quality data is the backbone of effective AI. We provide comprehensive annotation, pre-processing, qualitative and quantitative analysis, statistics and report generation services.
Clinical research support
Our AI-driven pipelines accelerate discovery and validation in biomedical and pharmaceutical research. We prepare technical documentation, analytics and data visualization for publications.
Software development, design and integration
We develop unique tools well fit into clinical/research workflow, local software solutions for internal systems or web interfaces to upload or process medical images. We design personalized custom easy-to-use UI and provide long-term support.